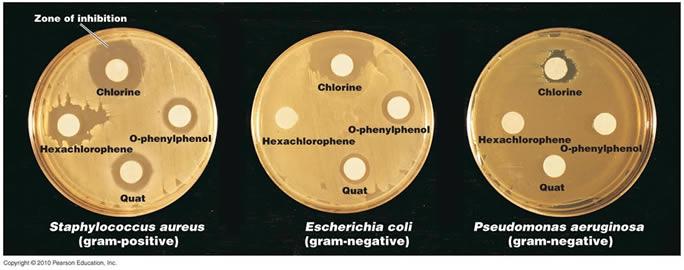

Which of the following is the best method to sterilize heat-labile solutions
membrane filtration
which of the following best describes the pattern of microbial death
the cells in a population die at a constant rate
which of the following substances is used for surgical hand scrubs
chlorhexidine
which of the following pairs of terms is mismatched
bateriostatic -- kills vegetative bacterial cells
the antimicrobial activity of chlorine is due to which of the following
the formation of hypochlorous acid
which of the following regarding antimicrobial control agents is false
alcohols effectively inactivate nonenveloped viruses by attacking lipids
which of the following does not achieve sterilization
pasteurization
which of the following is a limitation of the autoclave
it cannot be used with heat-labile materials
an agent used to reduce the number of bacteria on a toilet would most accurately be called
disinfectant
application of heat to living cells can result in all of the following except
decreased thermal death time
which of the following disinfectant acts by disrupting the plasma membrane
bisphenols
all of the following substances are effective against nonenveloped viruses except
alcohol
which of the following methods is used to preserve food by slowing the metabolic processes of foodborne microbes
freezing
which concentration of ethanol is the most effective bactericide
70%
all of the following factors contribute to hospital-acquired infections except
all of these factors may contribute to hospital-acquired infection
some bacteria metabolize disinfectants
gram-negative bacteria are often resistant to disinfectant
invasive procedures can provide a portal of entry for bacteria
bacterial may be present in commercial products such as mouthwash `w
which of the following treatments is the most effective for controlling microbial growth
they are equivalent treatments
which of the following could be used to sterilize plastic petri plates in a plastic wrapper
gamma radiation
In figure 7.1 what is the thermal death time

60 minutes
In figure 7.1 the thermal death point for this culture is

answer cannot be determined
in figure 7.1 the decimal reduction time (D value) for the culture, which is defined as the time to reduce a population by one log, is approximately

10 minutes
which of the following results in lethal damage to nucleic acids
heat, radiation, and some chemicals
in table 7.1 which compound was the most effective against staphylococcus

C
in table 7.1 which compound was bactericidal

answer cannot be determined
all of the following substances are used to preserve foods except
biguanides
all of the following are effective for destroying prions except
boiling
all of the following are methods of food preservation except
microwaves
which of the following is most resistant to chemical biocides
gram-negative bacteria
the thermal death time is the time needed to kill all the bacteria in a particular culture at a certain temperature
true
pseudomonas has been found growing in quarternary ammonium compounds
true
moist heat destroys organisms by denaturing proteins
true
some antimicrobial chemicals are considered to be disinfectants and antiseptics
true
the pH of the medium has no effect on the activity of the disinfectant being applied
false
autoclaving is the most effective method of moist heat sterilization
true
microorganism placed in high concentrations of salts and sugars undergo lysis
false
sterilization
removal or destruction of all microorganism
sterilant
sterilizing agent
commercial sterilization
limited heat treatment
disinfectant
control directed at destroying harmful microorganisms
antisepsis
when treatment is directed at living tissue
degerming
when the skin is swabbed with alcohol before vaccination
sanitization
intended to lower microbial counts
biocide/gemicide
kills microorganisms
sepsis
bacterial contamination
what is the rate of microbial death
the number of microbes
environmental influences
time of exposure
microbial characterisitics
What is thermal death point
the lowest temperature at which all the microorganisms in a particular liquid suspension will be killed in 10 minutes
What is thermal death time
the minimal length of time for all bacteria in a particular liquid culture to be killed at a given temperature
what is decimal reduction time
time in which 90% of a population of bacteria at a given temperature will be killed
how does moist heat kill microorganisms
by coagulating proteins
what is an autoclave
preferred method of sterilization in health care environments
what are retorts
large industrial autoclaves
pressure and temperature in an autoclave
higher the temperature (121oC), the higher the pressure (150lbs/psi)
pasteurization
elimination of pathogenic microbes
thermoduric
heat-resistant bacteria
high temperature short-time pasteurization
most milk pasteurization uses temperature of 72oC but for only 15 secs
also lower bacterial counts
utlra-high-temperature treatments
method of treating foods with high temperature for short times
equivalent treatments
as temperature rises, less time is needed to kill same number of microbes
hot air sterilization
items are placed in an oven for longer period, higher temperature is required
filtration
passage of a liquid/gas through a screenlike material with pores small enough to retain microorganisms
high-effeciency particulate are filters
remove almost all microorganisms larger than about 0.3um in diameter
phenol

phenol was used to control surgical infections in the operation room.
phenolics
derivative of phenol, contains a molecule of phenol that is chemically altered to reduce its irritation qualities and increase antibacterial activity
cresols
most frequently used phenolics
bisphenol
contain 2 phenolic groups, hexachlorophenes and triclosan
hexachlorophenes
is an ingredient of a prescription lotion, pHisoHex, used for surgical and hospital microbial control procedure
triclosan
is an antibacterial soap
what forms when chlorine is combined with water
hypochlorous acid
Cl2 + H2O <-> H+ + Cl- + HOCl
quaternary ammonium compounds
most used surface active agents
what is sodium hypochlorite used as
a household disinfectant and bleach
what is potassium sorbate and benzoate used for
to prevent molds from growing on acidic foods
what is calcium propionate used for
it is an effective fungistat used in bread
evaluation of disinfectants by the disk-dilution method